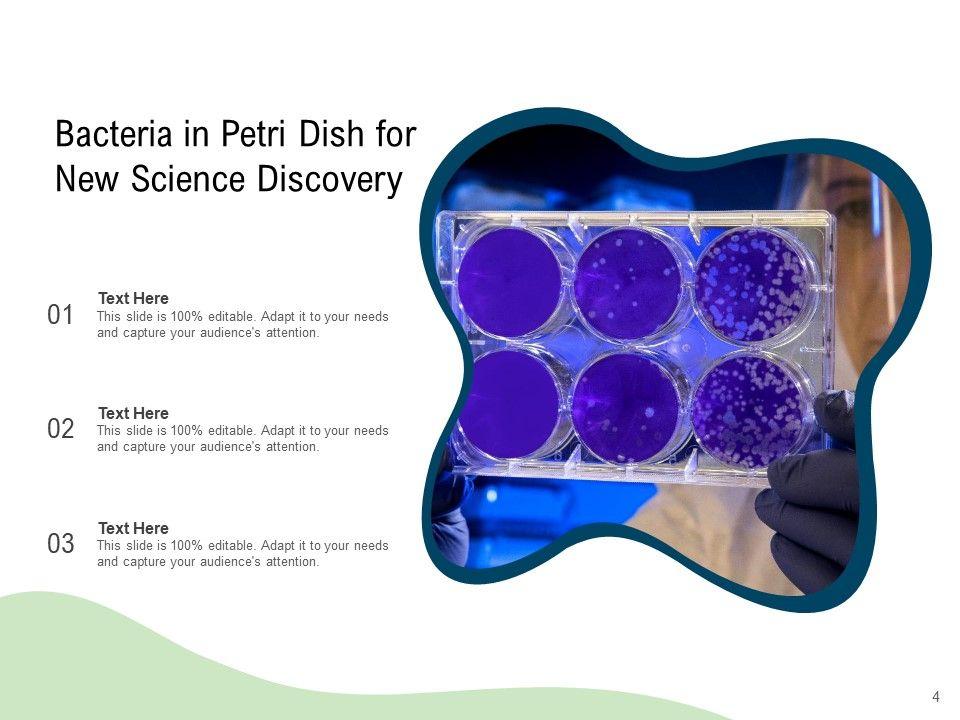
default_img

AI PPT Maker
Templates
PPT Bundles
Design Services
Business PPTs
Business Plan
Management
Strategy
Introduction PPT
Roadmap
Self Introduction
Timelines
Process
Marketing
Agenda
Technology
Medical
Startup Business Plan
Cyber Security
Dashboards
SWOT
Proposals
Education
Pitch Deck
Digital Marketing
KPIs
Project Management
Product Management
Artificial Intelligence
Target Market
Communication
Supply Chain
Google Slides
Research Services
One PagersAll Categories
Features of these PowerPoint presentation slides:
This microbiology magnifying glass medical science ppt powerpoint presentation complete deck acts as backup support for your ideas, vision, thoughts, etc. Use it to present a thorough understanding of the topic. This PPT slideshow can be utilized for both in-house and outside presentations depending upon your needs and business demands. Entailing twelve slides with a consistent design and theme, this template will make a solid use case. As it is intuitively designed, it suits every business vertical and industry. All you have to do is make a few tweaks in the content or any other component to design unique presentations. The biggest advantage of this complete deck is that it can be personalized multiple times once downloaded. The color, design, shapes, and other elements are free to modify to add personal touches. You can also insert your logo design in this PPT layout. Therefore a well-thought and crafted presentation can be delivered with ease and precision by downloading this microbiology magnifying glass medical science ppt powerpoint presentation complete deck PPT slideshow.
People who downloaded this PowerPoint presentation also viewed the following :
Keywords:
Related Products
Microbiology Magnifying Glass Medical Science Ppt PowerPoint Presentation Complete Deck with all 12 slides:
Ratings and Reviews
4.5
- ★51
- ★41
- ★30
- ★20
- ★10
Write a review
Most Relevant Reviews
by Hanisha Kapoor
January 29, 2021
Professional and unique presentations.by Kirti Jindal
January 29, 2021
Out of the box and creative design.
View per page:
10